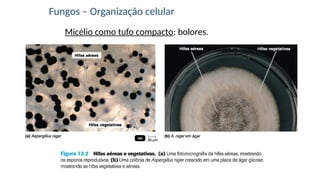
Micélio como tufo compacto: bolores.
Fungos – Organização celular

O documento aborda a microbiologia de fungos e protozoários, descrevendo suas características, importância ecológica, e mecanismos de patogenicidade. Inclui a filogenia dos eucariotos e informações sobre fármacos antifúngicos, além de detalhes sobre a reprodução, nutrição e doenças associadas a esses organismos. O material é fundamentado em diversas referências científicas e exemplifica a diversidade e o impacto desses microrganismos nos ecossistemas.

![Nutrição
o Temperatura e pH ótimo de crescimento: 25o
C e 5,0.
o Maioria aeróbia. Leveduras – anaeróbia facultativa.
o Resistentes à pressão osmótica – crescem em [ ] altas
de açúcar ou sal.](https://image.slidesharecdn.com/aula8-fungoseprotozoarios2023-2-241101181918-135f6dc6/85/Fungos-e-Protozoarios-Aula-de-Microbiologia-19-320.jpg)



































